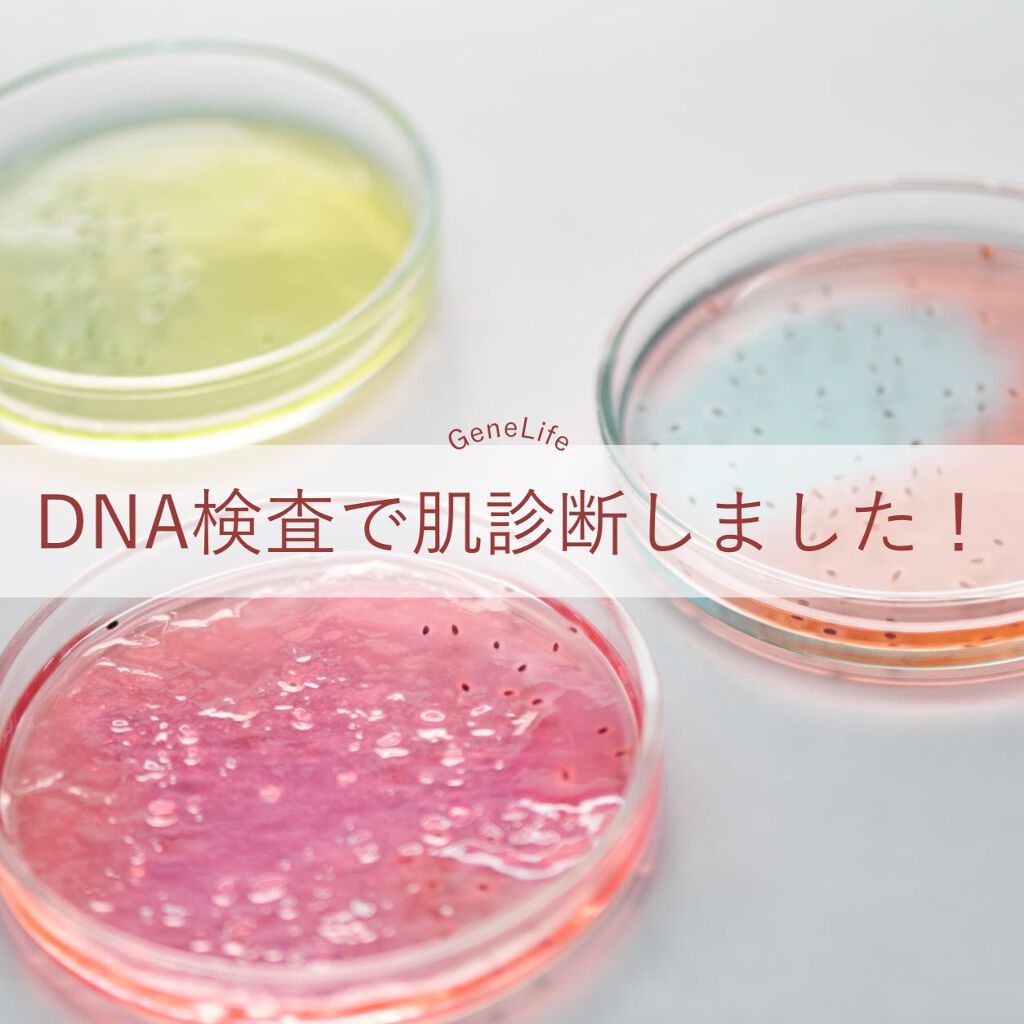
を使ったクチコミ（1枚目）

.SerumNavi遺伝的肌タイプ診断SerumNavi(セラムナビ)は、遺伝的に肌に必要な美容成分を提案する新しい遺伝子検査サービス🧬しみ、しわに関係する2種類の遺伝子を検査し、以下の4タイプに分類してくれるよ🔍・ノーリスク型・しわリスク型...
もっと見る遺伝子検査キットランキング
| 商品画像 | 商品情報 | 参考価格 | 評価 | ランキングIN | 特徴 | 商品リンク |
|---|---|---|---|---|---|---|
chatGENE chatGENE |
| ウェルネスランキング第114位 | 詳細を見る | |||
MY SKIN ID 肌遺伝子検査キット MY SKIN ID | 5,500円 |
| 遺伝子検査キットランキング第3位 | めちゃくちゃ簡単に検査できるし、オススメ♥ | 詳細を見る | |
SNPs Go! Serum Navi |
| 遺伝子検査キットランキング第4位 | 詳細を見る |
kana-cafeさんの人気クチコミ
「カウブランド無添加保湿化粧水しっとりタイプ」 (175ml税込み1,320円)@mutenka_official牛乳石鹸が100年培ってきたやさしさのブランド「カウブランド」敏感肌の方だけでなくお肌に良いものを求めるすべての人のために誕生し...
もっと見る
112
1
- 2021.05.10
VTコスメティクス様「VTCICAクリーム」@vtcosmetics_japan@vtcosmetics_officiaVTcosmeticsCICAクリーム 50ml 価格:2,730円(税込)カサカサと敏感肌のためにお肌をしっかり整えてく...
もっと見る
100
0
- 2021.05.16
新メンズスキンケアブランド 「DISM(ディズム)」スターターセット《税込み4,400円》「スカルプD」でお馴染みのアンファー様から2021年4月21日に新発売されたメンズスキンケアブランド 「DISM(ディズム)」スターターセット《税込み4...
もっと見る
97
2
- 2021.05.10
SK-Ⅱ様「ジェノプティクスウルトオーラエッセンス」@skii美白美容液<医薬部外品>SK-IIジェノプティクスウルトオーラエッセンス30ml・18,480円(税込)/50ml・26,400円(税込)/75ml・37,400円(税込)※画像は...
もっと見る
96
2
- 2021.06.02
「BEAUTYAVENUE(生ジェルネイルシール)」@beautyavenue.jpおうち時間にサロン級の仕上がり♡貼って硬化させるだけの簡単「生ジェルシール」の「BEAUTYAVENUE」初心者でも貼りやすい柔らかさだから5分で簡単に自宅で...
もっと見る
96
2
- 2021.06.17
「Lement(ルメント)リペアミルク」@lement_officialドライヤーの熱に反応することによってダメージ補修し、うるおいと輝きに満ちた髪に導く。髪に負担になるドライヤーやアイロンの熱を逆手に取った逆発想のミルクトリートメント♫・ヒ...
もっと見る
95
3
- 2021.08.30
![LIPS[リップス] - コスメのクチコミ検索アプリ](https://cdn.lipscosme.com/assets/lips_logo_full_2022-bc7b4bc9dd66035bc5696b0d16bc3d38a7be357186656c039e68cc4cf21ae675.png)

コメント